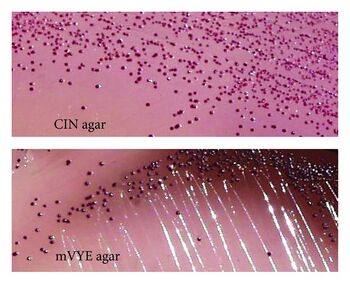

Far East Scarlet-Like Fever
 From Mdwiki
From Mdwiki | Far East scarlet-like fever | |
|---|---|
| Other names: Scarlatinoid fever | |
 | |
| Mesenteric adipose tissue days after Yersinia pseudotuberculosis infection | |
| Specialty | Infectious disease |
Far East scarlet-like fever is an infectious disease caused by the gram negative bacillus Yersinia pseudotuberculosis. In Japan it is called Izumi fever.[1]
Signs and symptoms[edit | edit source]
- Red skin rash usually of the face, elbows, and knees
- Skin desquamation
- Exanthema
- Red tongue
- Toxic shock syndrome
Other features include mesenteric lymphadenitis and arthritis. Kidney failure rarely occurs. Relapses occur in up to 50% of patients. Enterocolitis is common in children. Sepsis occasionally occurs; it primarily occurs in patients with preexisting comorbidities such as diabetes mellitus, liver cirrhosis, or hemochromatosis. Postinfective complications include reactive arthritis, erythema nodosum, iritis, and glomerulonephritis.
Cause[edit | edit source]
The cause of this disease is Yersinia pseudotuberculosis serotype O1. 95% are subtype O1b.[citation needed]
Yersinia pseudotuberculosis has been divided into 6 genetic groups: group 1 has only been isolated from the Far East.[4]
Pathophysiology[edit | edit source]
The clinical features of this disease appear to be due—at least in part—to the production of a superantigen—YpM (Yersinia pseudotuberculosis-derived mitogen). This is present in almost all strains from the Far East but only 20% of European isolates.[5] The antigen was discovered in 1993 and is encoded by a 456-base gene. The protein has 151 amino acids, with a signal sequence of 20 amino acids. The mitogenic antigens are scattered across the protein but two cysteine residues (residues 32 and 129) which form a disulfide bridge are critical.[citation needed]
The G+C content of this gene is 35%—lower than the genomic average (47%) suggesting that this gene has been acquired from some other organism.[5] The organism from which this gene originated has not yet been identified. This gene seems likely to have been introduced into the genome by a bacteriophage, given the nearby presence of a phage integration site, but the mechanism of entry into the genome is not currently known.[citation needed]
Diagnosis[edit | edit source]
In terms of the diagnosis of East scarlet-like fever, we find evaluation is on basis of bacteriological study of sectional material[6]
Differential diagnosis[edit | edit source]
The main differential diagnosis is scarlet fever.[7]
Treatment[edit | edit source]
In terms of the treatment of the cause of this disease, we find that ampicillin, ceftriaxone, doxycycline, and gentamycin are used[8]
History[edit | edit source]
The first outbreak of this disease was reported from the Pacific coastal areas (Primorsky Krai) of Russia in the 1950s.[citation needed]
References[edit | edit source]
- ↑ Sato K, Ouchi K, Taki M (1983) Yersinia pseudotuberculosis infection in children, resembling Izumi fever and Kawasaki syndrome. Pediatr Infect Dis 2: 123–126
- ↑ Zalmover IIu, Znamenskiĭ VA, Ignatovich VO, Vishniakov AK, Serov GD (1969) Clinical aspects of Far Eastern scarlatina-like fever. Voen Med Zh 1:47–51
- ↑ Solozhenkin VG (1978) Scarlet fever-like disease in children. Pediatriia (1):27–28
- ↑ Fukushima H Matsuda Y, Seki R, Tsubokura M, Takeda N, Shubin FN, Paik IK, Zheng XB (2001) Geographical heterogeneity between Far Eastern and Western countries in prevalence of the virulence plasmid, the superantigen Yersinia pseudotuberculosis-derived mitogen, and the high-pathogenicity island among Yersinia pseudotuberculosis strains. J Clin Microbiol 39:3541–3547
- ↑ 5.0 5.1 Yoshino K, Ramamurthy T, Nair GB, Fukushima H, Ohtomo Y, Takeda N, Kaneko S, Takeda T (1995) Geographical heterogeneity between Far East and Europe in prevalence of the ypm gene encoding the novel superantigen among Yersinia pseudotuberculosis strains. J Clin Microbiol 33(12) 3356–3358
- ↑ Somova, Larisa M.; Antonenko, Fedor F.; Timchenko, Nelly F.; Lyapun, Irina N. (2 June 2020). "Far Eastern Scarlet-Like Fever is a Special Clinical and Epidemic Manifestation of Yersinia pseudotuberculosis Infection in Russia". Pathogens. 9 (6): 436. doi:10.3390/pathogens9060436. ISSN 2076-0817. Archived from the original on 16 February 2024. Retrieved 15 February 2024.
- ↑ Antonov VS (1978) Differential diagnosis of scarlet fever-like forms of pseudotuberculosis and scarlet fever in children. Pediatriia 52(1):6–9
- ↑ Brady, Mark F.; Yarrarapu, Siva Naga S.; Anjum, Fatima (2023). "Yersinia Pseudotuberculosis". StatPearls. StatPearls Publishing. Archived from the original on 15 June 2022. Retrieved 8 June 2023.
Categories: [Bacterial diseases] [Scarlet fever]
↧ Download as ZWI file | Last modified: 02/17/2024 15:26:35 | 3 views
☰ Source: https://mdwiki.org/wiki/Far_East_scarlet-like_fever | License: CC BY-SA 3.0
KSF
KSF